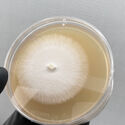
Materiales de micelio: El futuro de cultivar nuestros hogares - Imagen 2 de 7

Los hongos están casi en todas partes: en el aire que respiramos, en el suelo que pisamos, los comemos y sí, también viven dentro de nosotros.
En el ámbito de la biotecnología industrial, los hongos, como la levadura, se utilizan habitualmente como catalizadores en bioprocesos como la elaboración de cerveza o la panadería. Sin embargo, los hongos son capaces de mucho más. En la naturaleza, el reino fúngico representa el grupo más abundante de organismos que desempeñan varias funciones importantes, como la degradación de la materia orgánica muerta, el suministro de nutrientes a las plantas, la desintoxicación del suelo y la depuración del agua de metales pesados. Algunas especies de hongos se han utilizado para el desarrollo de fármacos (antibióticos), y los andamios compuestos de hongos se aplican en biomedicina[1]. En la medicina china, el shiitake, el reishi, así como otros hongos, se utilizan desde hace tiempo con fines medicinales o nutricionales.
En la actualidad, la industria de la biotecnología fúngica está experimentando un renacimiento y está ayudando a crear una economía circular mediante la transición de una basada en el petróleo a una basada en los recursos biológicos. La reciente producción a escala industrial, competitiva en costes y respetuosa con el medio ambiente, de materiales cultivados con micelio para las industrias de la construcción, el mobiliario, el transporte y el embalaje tiene el potencial de contribuir significativamente a los Objetivos de Desarrollo Sostenible de las Naciones Unidas[2]. La valorización de los residuos lignocelulósicos con alto contenido en lignina y celulosa parece especialmente prometedora para el desarrollo de materiales compuestos (Ecovative Design, Mushroom Packaging), fibras (MycoWorks), membranas o incluso cuero (Mylo, Bolt Threads). De ahí que la exploración de especies fúngicas y el desarrollo de tecnologías para producir materiales a base de micelio sigan aumentando.
¿Qué es el micelio?
El cultivo de hongos es un proceso biotecnológico. Los materiales a base de micelio se fabrican seleccionando los componentes deseados (especies, sustratos) y siguiendo un proceso de síntesis específico. Los hongos de la podredumbre blanca, como el Ganoderma lucidum y el Pleurotus ostreatus, pueden descomponer los mismos polímeros naturales para luego absorberlos y crecer. Estas especies de hongos pueden crecer en varios sustratos: materias primas agrícolas como paja, granos, gránulos de café o serrín. Requieren también suficiente agua. El crecimiento de la red fúngica se inicia mediante la inoculación (Figura 1) utilizando un germen de hongo. Mediante el desarrollo de hifas, el hongo crea una red de micelio interconectado que rodea y conecta el material para formar un compuesto autoportante. Las técnicas asépticas, así como el control de las condiciones termodinámicas (temperatura, humedad, acceso al oxígeno y a la luz) son intrínsecas al diseño del proceso y conformarán la formación y las propiedades del biomaterial.

Los filamentos del micelio se denominan hifas, que están formadas por células alargadas. La pared celular del micelio está formada por quitina, glucanos, proteínas y lípidos, cuya concentración depende del sustrato de alimentación que, en última instancia, define las propiedades de los materiales sintetizados[3]. Las materias primas lignocelulósicas están compuestas por aproximadamente un 60-70% de azúcares fermentables y un 20-30% de compuestos aromáticos que los hongos filamentosos como Pichia spp o Fusarium spp son expertos naturales en procesar[4]. Mediante la secreción de enzimas específicas, los hongos pueden acceder a los nutrientes (carbono, nitrógeno, etc.) y, en última instancia, romperán las redes de polisacáridos que sirven de láminas estructurales que rodean las hifas[5]. Así pues, el micelio es una mezcla tenaz de matrices de quitina-glucano y reticulación filamentaria intracelular. Después de la colonización completa, los cuerpos fructíferos característicos de las especies de Basidiomycota surgirán en la parte superior de la estructura micelial. El procedimiento de cultivo puede interrumpirse en el momento necesario mediante tratamiento térmico o secado. En comparación con otros materiales avanzados (conductores o electrónicos, compuestos inorgánicos, polímeros), los biocompuestos fúngicos requieren un proceso de fabricación significativamente simplificado, al tiempo que ofrecen una libertad de diseño y una funcionalidad sin precedentes.
¿Cómo crear material de micelio con diferentes propiedades?
En primer lugar, las propiedades funcionales del material de micelio pueden ajustarse según su necesidad y uso. Los materiales de micelio puro presentan diferentes propiedades estructurales en función de la cepa fúngica, el sustrato, las condiciones de crecimiento y el procesamiento posterior a la síntesis. Las propiedades mecánicas suelen estar definidas por la especie (morfología): el micelio fibroso alargado tiene más elasticidad y, por tanto, puede utilizarse para el mico-cuero; en cambio, con el micelio más duro pueden obtenerse materiales de construcción más resistentes que el hormigón.
En segundo lugar, en combinación con técnicas de procesamiento controladas, se puede utilizar una variedad de sustratos y aditivos para unir partículas lignocelulósicas discretas en compuestos de micelio con geometría definida (Figura 2). Todas las materias primas y los aditivos de origen orgánico contribuyen a la biodegradabilidad del producto al final de su vida útil[6]. Curiosamente, algunos grupos de hongos producen materiales no tóxicos al degradar los compuestos tóxicos, como los terpenos, del sustrato de alimentación[7]. Estos atributos ayudan a introducir nuevas formas de crear materiales ecológicos, así como a reducir la necesidad de productos químicos duros y agentes colorantes y, por tanto, a reducir los costes de producción.

A continuación, examinamos los parámetros del proceso y el postratamiento. La interacción entre los hongos de podredumbre blanca y su materia prima, así como las variables del proceso durante la fabricación (protocolo, esterilización, inoculación, envasado, incubación, periodo de crecimiento y método de secado) son fundamentales para el diseño y el desarrollo del producto[8]. El nivel adecuado de temperatura, humedad y luz (o su ausencia) contribuyen a la formación y funcionalidad del producto final. Por ejemplo, el desarrollo de una red micelial más densa puede hacer que el material sea más duradero, la adición de dextrosa puede hacer que el material sea más elástico, y los minerales especiales pueden reducir el apetito de roedores e insectos. Es importante señalar que el micelio fúngico repele el agua. El aumento de peso por absorción de humedad se produce principalmente en las materias primas residuales[9].

Una vez que el producto se ha introducido completamente en el molde, se seca completamente para detener su crecimiento, o se seca parcialmente para que pueda rehidratarse y crecer en las partes adyacentes, formando así una única sección fabricada. Aplicando el prensado en frío o en caliente, se pueden mejorar las propiedades estructurales de los compuestos a base de micelio. El prensado aumenta la densidad del material y reduce la porosidad. También ayuda a reorientar las fibras horizontalmente en un plano y reduce su grosor, aumentando así el contacto entre las fibras superpuestas[10]. El material puede tratarse además con aceites naturales para hacerlo más duradero.
¿Cuáles son las aplicaciones de los materiales fúngicos?
Partiendo de lo anterior, el diseño y la ingeniería de materiales bioinspirados presenta un área de investigación muy madura, dados los complejos materiales que la biología es capaz de producir. Además de ser rentables, biodegradables y menos densos e impactantes para el medio ambiente, los materiales fúngicos tienen muchas otras ventajas sobre los materiales tradicionales. Debido a su alta absorción acústica, baja conductividad térmica y resistencia al fuego, los materiales basados en micelio se han comparado con el poliestireno expandido (EPS), una espuma a base de petróleo utilizada para el aislamiento térmico en la industria de la construcción[11,12]. Además, la estructura porosa del micelio es beneficiosa para el rendimiento del aislamiento térmico. Existen varias patentes sobre materiales compuestos fabricados a partir de micelio en el segmento de la automoción y el embalaje[13]. Además de sus diversos atributos funcionales para usos en las industrias textil, del embalaje, del aislamiento o de la automoción, los elementos de decoración interior a base de micelio tienen diseños excepcionalmente extravagantes (Figura 3).

Nuestros estudios y pruebas hasta ahora muestran que el material de micelio tiene una gran resistencia (más fuerte que el EPS), al mismo tiempo que grandes propiedades de aislamiento similares a la fibra de vidrio o la lana de oveja (conductividad térmica, λ = 0,04 W/mk), propiedades acústicas regulables, así como una alta resistencia al fuego en comparación con otros materiales orgánicos. Obtener características similares o mejores que las alternativas de materiales compuestos y plásticos es fundamental para su adopción masiva. Según nuestra experiencia, es necesario realizar una gran labor educativa en el mercado, ya que las industrias tradicionales suelen ser lentas a la hora de adoptar estas soluciones novedosas. Los atributos funcionales de los materiales de micelio pueden explicarse en el contexto de su aplicación. De ahí que las pruebas comparativas específicas que se han mencionado antes sean fundamentales para la viabilidad financiera y la transferencia de conocimientos. Los estudios de prueba de concepto con universidades (Figura 4), junto con clientes piloto, ayudan a impulsar las colaboraciones en un ámbito más amplio.

¿Cuál es la huella medioambiental de los materiales de micelio?
Una nueva clase de biomateriales producidos por biotecnología fúngica podría sustituir pronto a los plásticos, espumas, textiles y otros materiales derivados de recursos petrolíferos[14]. En términos de huella de carbono y sostenibilidad, los productos de micelio tienen una ventaja sobre sus homólogos sintéticos, especialmente en aplicaciones de un solo uso. La huella medioambiental es la tesis central del material de micelio, ya que se puede decir que el cultivo de micelio es carbono negativo. Para llegar a esta conclusión, utilizamos una metodología llamada Análisis del Ciclo de Vida (ACV) que examina todo el ciclo de vida del producto, desde la cuna hasta la tumba. En concreto, este análisis tiene en cuenta todos los materiales utilizados en la producción, la logística, la energía, el transporte, el embalaje y la vida final de los productos. A cada uno de estos pasos e insumos se les asignan equivalentes de CO2, lo que significa que podemos cuantificar la producción de CO2 de todo el ciclo de vida, así como comprender qué pasos necesitan mejoras para reducir la huella medioambiental del producto.
Pero, ¿cómo podemos justificar que sea carbono negativo? Tomemos nuestra materia prima más popular, el aserrín. Cada kilo de madera contiene 1,5 kg de CO2 cuando se libera, y normalmente se utiliza para obtener energía simplemente quemándola. Nuestra producción en su conjunto emite menos de 0,5 kg de CO2 por cada kilo de material de setas. Dado que el micelio realmente aglutina carbono, cada kilogramo contiene aproximadamente 1 kg de CO2. Para ser justos, al final del ciclo de vida del producto, el carbono se libera de nuevo al medio ambiente. Sin embargo, al ser de origen natural y compostable, es un alimento para la tierra (en comparación con la mayoría de nuestros materiales más problemáticos). Los principales aspectos medioambientales de los materiales de micelio:
- Vida posterior perfecta: 100% natural y compostable tras su uso (si no se trata con productos químicos);
- Producción de baja energía: el material del micelio crece por sí mismo a 25 grados;
- Economía circular: utilizamos los restos orgánicos de otras industrias, como aserrín, heno, virutas de cáñamo, bagazo de cerveza, residuos de café, etc;
- Ambiente seguro y natural, los materiales de micelio no causan alergias ni emiten toxinas, el material es inerte cuando se le proporcionan condiciones relativamente secas y estables.
Para concluir, los materiales de micelio presentan una gran solución para la corta rotación de carbono y la reciclabilidad. La necesidad de materiales sostenibles crece al darse cuenta de la crisis en la que nos encontramos, ya sea ambiental, económica o geopolítica. Como los cambios son dolorosos, es necesario mostrar ejemplos de éxito para acelerar el periodo de adopción. La tecnología está aquí, pero ¿habrá suficiente fuerza de voluntad para llegar a un punto en el que en lugar de construir nuestras casas las cultivemos?
Myceen es una entidad de investigación y diseño sostenible centrada en el desarrollo de materiales basados en micelio de hongos. Estos materiales negativos en carbono y compostables se cultivan combinando micelio y subproductos orgánicos. Los micromateriales pueden sustituir potencialmente a los plásticos y los compuestos problemáticos, al tiempo que valorizan los restos de otras industrias.
Actualmente se centran en los muebles y los productos de interior, pero también investigan la posible aplicación del material en el sector de la construcción.
Más información: https://www.myceen.com/

[1] Vandelook, S., Elsacker, E., Van Wylick, A. et al. Current state and future prospects of pure mycelium materials. Fungal Biol Biotechnol 8, 20 (2021). https://doi.org/10.1186/s40694-021-00128-1
[2] BioMed Central Ltd. Connecting material science and fungal biology. Springer Nature, 2022. https://www.biomedcentral.com/collections/cmsfb
[3] Ruiz-Herrera, J., & Ortiz-Castellanos, L. (2019). Cell wall glucans of fungi. a review. The Cell Surface 5, 100022. https://doi.org/10.1016/j.tcsw.2019.100022
[4] Hyde, K. D., Xu, J., Rapior, S., Jeewon, R., Lumyong, S., Niego, A. G. T., … Brooks, S. (2019). The amazing potential of fungi: 50 ways we can exploit fungi industrially. Fungal Diversity. https://doi.org/10.1007/s13225-019-00430-9
[5] Haneef, M., Ceseracciu, L., Canale, C., Bayer, I. S., Heredia-Guerrero, J. A., & Athanassiou, A. (2017). Advanced Materials From Fungal Mycelium: Fabrication and Tuning of Physical Properties. Scientific Reports, 7(1). https://doi.org/10.1038/srep41292
[6] Manan, S., Ullah, M. W., Ul-Islam, M., Atta, O. M., & Yang, G. (2021). Synthesis and applications of fungal mycelium-based advanced functional materials. Journal of Bioresources and Bioproducts, 6(1), pp. 1–10. https://doi.org/10.1016/j.jobab.2021.01.001
[7] Chambergo, F. S., & Valencia, E. Y. (2016). Fungal biodiversity to biotechnology. Applied Microbiology and Biotechnology, 100(6), pp. 2567–2577. https://doi.org/10.1007/s00253-016-7305-2
[8] Vanden Elsacker, E., De Laet, L., & Peeters, E. (2019). Mycelium-based materials at the dawn of the Anthropocene. In Structures and Architecture - Bridging the Gap and Crossing Borders: Proceedings of the Fourth International Conference on Structures and Architecture (ICSA 2019), pp. 1083-1090. CRC Press, Taylor & Francis, Boca Raton. https://doi.org/10.1201/9781315229126-129
[9] Zhang, X., Hu, J., Fan, X., Yu, X. (2022). Naturally grown mycelium-composite as sustainable building insulation materials. Journal of Cleaner Production, 342, 130784. https://doi.org/10.1016/j.jclepro.2022.130784
[10] Thoemen, H., & Humphrey, P. E. (2005). Modeling the physical processes relevant during hot pressing of wood-based composites. Part I. Heat and mass transfer. Holz Als Roh- Und Werkstoff, 64(1), pp. 1–10. https://doi.org/10.1007/s00107-005-0027-2
[11] Pohl, C., Schmidt, B., Nunez Guitar, T. et al. (2022). Establishment of the basidiomycete Fomes fomentarius for the production of composite materials. Fungal Biol Biotechnol 9, (4). https://doi.org/10.1186/s40694-022-00133-y
[12] Kuznetsova, I.; Zaitsev, B.; Krasnopolskaya, L.; Teplykh, A.; Semyonov, A.; Avtonomova, A.; Ziangirova, M.; Smirnov, A.; Kolesov, V. (2020). Influence of Humidity on the Acoustic Properties of Mushroom Mycelium Films Used as Sensitive Layers for Acoustic Humidity Sensors. Sensors 2020, 20, 2711. http://dx.doi.org/10.3390/s20092711
[13] Cerimi, K., Akkaya, K. C., Pohl, C., Schmidt, B., & Neubauer, P. (2019). Fungi as source for new bio-based materials: a patent review. Fungal Biology and Biotechnology, 6 (1). https://doi.org/10.1186/s40694-019-0080-y
[14] Meyer, V., Basenko, E. Y., Benz, J. P., Braus, G. H., Caddick, M. X., Csukai, M., Wösten, H. A. B. (2020). Growing a circular economy with fungal biotechnology: a white paper. Fungal Biology and Biotechnology, 7(1). https://doi.org/10.1186/s40694-020-00095-z